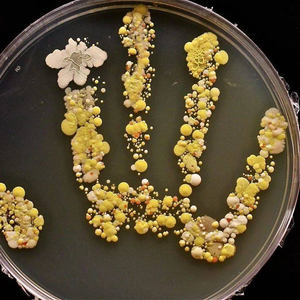

原标题:人是微生物的寄生兽吗 来源:大象公会©
本文来自微信公众号:大象公会(ID:idxgh2013),作者:朱不换,题图来自视觉中国
你的身体里有多少微生物?
多到吓人。
即使不把病毒计算在内,这些微生物也有大约一百万亿,是人体自身细胞总数的 1.3 至 3 倍。也就是说,人体内微生物数量比人体细胞的数量要多得多。如果人体内搞一场细胞尺度的大选,细菌、真菌才是人体内的主要人口。

这还只是从个体计数的角度计算。如果从基因传承的角度看,那就更加夸张。人类只有两万个基因。而根据对人体肠道菌群的估测,人体中含有约两百万个微生物基因,是人类基因数量的 100 倍。
如果说基因是支配细胞活动和繁衍的“法典”,那么当翻开人体内的基因法典,你会发现只有前几页由人类书写,后面 99% 的页面是细菌、真菌等微生物书写的。
那么,做人岂不是很可怜?辛苦奔忙,原来只是养活了一身的细菌?到头来,连体内基因都被微生物给“绿”了?
人和这些微生物到底是什么关系?人是微生物的寄生兽吗?
人和微生物的长期共生
人和体内微生物之间是长期共生关系。
而长期共生的物种之间的利害互动可以分为几种类型:互惠 (利你利我),偏利共生 (我借你的光,但你没什么损失),偏害共生 (我伤害了你,但我也没得到什么),中立 (互不影响),寄生 (损你利我)和竞争 (争夺资源)。

而在人和体内定居的微生物之间,这种关系一般是对微生物有利的。因为哪里有营养,微生物就会去哪里,人体为微生物提供了营养和宜居环境,相当于一片水草丰美的大地。
这样,人和体内微生物的关系大体可以落入左侧的互惠,偏利共生和寄生三类。
比如,人和肠道短双歧杆菌的关系是互惠。人给了短双歧杆菌营养,而短双歧杆菌可以助人防止便秘,腹泻和肠易激综合症。

酸菜,酸奶等食物富含短双歧杆菌
人和表皮葡萄球菌等许多细菌的关系是偏利共生。健康人的体表有大量的表皮葡萄球菌,它们从人的体表汲取营养残余,但人通常也没什么损失。

表皮葡萄球菌
人和结核分歧杆菌的关系则是病原体寄生,结核分歧杆菌感染人体后能引起结核病。

结核病患者
健康人的身体之所以能容纳百万亿计的微生物,是因为大多数这些微生物都在人体上和平生活,大部分时候没什么害处,部分微生物还对人体有好处。
不过,人和每种微生物之间的关系并不是固定的。朋友可以变成敌人,敌人也可以变成朋友。
甚至人体细胞中源于微生物的古老功臣——线粒体,有时也会造反。
被招安的线粒体
人类的远祖最早融合驯化的细菌,可能是线粒体。20多亿年前,一枚古菌吞噬了一枚细菌,但它并没有把细菌消化掉,而是让细菌在自己体内提供化学能量,充当自己的“发电机”。这枚被收编的细菌,就是如今遍布所有动植物细胞内的线粒体。

研究发现,人体内的线粒体与细菌普氏克立次体的基因和功能高度相似。未被驯化的普氏克立次体是流行性斑疹伤寒的元凶,而驯化了的线粒体却在人体内默默“发电”,是人体细胞瞬时能量的提供者。
不过,线粒体虽然已是人体细胞的细胞器之一,但也仍未被彻底同化:它仍保留了一部分自己独特的基因片段,而人体的免疫系统也依然不把线粒体当成“自己人”。
当人体细胞受伤破裂时候,线粒体片段会闯入血液,遭受人体免疫系统的集体攻击。如果人体破损细胞释放出的线粒体太多,还可能引发全身性炎症反应,有可能危及生命。
人和体内许多微生物的关系,和线粒体的情况相当相似。互相需要,但又要互相提防着。
当微生物栖息在合适的器官时,能帮助人消化营养,促进免疫系统等,但当这些微生物外泄到另一些器官时,就可能引起或轻微或严重的疾病。
体内微生物的分布
实际上,人的不同器官和部位,都有各自的特色菌群。这些器官不同的温度、酸碱度、含氧量等“水土条件”,吸引养育了不同的菌群。
比如皮肤上的微生物主要有丙酸杆菌、棒状杆菌和葡萄球菌;肠道中的主导微生物是拟杆菌,阴道中的则是乳酸杆菌,而占据口腔的主要是链球菌。
人体的各个器官按照微生物活跃程度,可以分为几档。
微生物最稀少的地方,是子宫和大脑。子宫因为负担孕育胎儿的重任,具有近乎无菌的环境。因为血脑屏障的保护,大脑也是微生物稀少的器官。

大脑中的血脑屏障(毛细血管壁和星形胶质细胞等)保护了精密娇嫩的大脑免受血液中病原体的感染。
微生物中等活跃的地方,是皮肤,呼吸道等地方,这些地方因为接触体外或交换空气等原因,有不少微生物。
而皮肤微生物的一大功能,是生产体味。
每一个人都有自己独一无二的体香或体臭。即使基因相同、面容酷似的同卵双胞胎,各自的体味也互不一样,因为体味来自皮肤菌群对汗腺、皮脂腺分泌物的作用,而每个人的体表菌群都不相同。
依靠嗅闻体味,婴儿可以辨认出母亲,父母可以辨认出亲生子女,而恋人会因体味触发心动的感觉。

微生物最活跃的地方,则是人的口腔、肠胃等消化道器官,因为它们最频繁接触食物中的细菌,而且相当依赖这些微生物来消化营养,制衡有害菌群等。
胃肠道:微生物的天堂
人的胃肠道中包含大量的食物残渣和水,对微生物来说简直是流着蜜的天堂。
而许多肠道微生物可以则帮助人类消化食物,释放出珍贵的营养。它们能生产我们难以自然获取的维生素,还能分解有毒有害的化学物质。

人体中的维生素K有近一半由肠道微生物合成
更重要的是,良性微生物能刺激肠道的正常发育和运行。它们能激活了小鼠体内的多种基因,让肠道得以建立上皮屏障、分解毒素、修建血管等等。
在无菌环境下长大的斑马鱼或小鼠,其肠道无法充分发育,肠壁容易渗漏,血管更稀疏,细胞再生能力也差。而喂食它们适量的微生物,则可以矫正这些弊病。
除此之外,微生物还具有一种人类望尘莫及的特异功能——横向基因转移。
对人类来说,基因传递总是纵向的,经过生育由父母传给子女,子女传给孙辈…… 你无法通过共同进食、输血、接吻获得另一个人的基因。
而微生物则不同,它们可以频繁的直接获得来自其他微生物的基因碎片,整合为自己的一部分。
例如,人类无法消化紫菜,人体肠道细菌也无法消化紫菜。但部分日本人因为千百年长期食用紫菜,他们肠道内的拟杆菌从紫菜上的海洋生物佐氏菌截取了基因碎片,获得了消化紫菜的能力。

而且,人类肠道因为营养丰富,微生物密集,相当于基因交换转移的繁荣集市。与外部环境中的细菌相比,人类内的细菌对之间交换基因的几率是前者的 25 倍。
这些活跃演化着的肠道菌群,对身体的影响难以估量。
它们甚至会影响人们服用药物的疗效。

比如最常见的止痛退烧药对乙酰氨基酚,不同的人服用后的效果不同,这是因为不同的人肠道菌群分布不同,而这会影响药物成分的吸收效果。
而抗癌药易普利姆玛、类风湿关节炎药物柳氮磺胺吡啶等,都需要肠道微生物辅助才能发挥作用。
而且,肠道菌群可以产生一系列乙酰胆碱,儿茶酚胺,γ-氨基丁酸,5-羟色胺等神经活性物质,会间接作用于大脑功能,影响人的情绪和心境。
实验室小鼠在移植了严重抑郁症患者的粪便后,也会表现出焦虑抑郁。而无菌饲养的的小鼠也更容易比普通小鼠患上焦虑和抑郁。
肠道菌群对人类情绪可能有类似的影响。优化肠道菌群,有可能改善焦虑、抑郁的心境。
那么,怎么才能获得良性的肠道菌群?
良性菌群从哪里来
人体内的微生物群,最初是来自父母。
婴儿一出生,就会立刻被母亲阴道内的微生物定植;新生儿体内几乎 3/4 的菌株都可以直接追溯到母亲。
接下来几个月,婴儿会从父母和周围环境中获得新的菌种。父母通过日常的抚触、喂食、环境布置,把自己的菌群也传给了幼儿。
在一岁至三岁之间,幼儿的肠道就可以演化到和成人相近的状态。
那么,已经长大的人,如果体内微生物群有缺陷,应该怎么补救?
简单的食用益生菌饮品往往并不太靠谱。因为流行的益生菌饮品中的乳酸杆菌等的种类较为单一;它们往往既不是人体中的天然菌群,也难以在人体肠道中定植。
稍好一点的方法,是均衡饮食,把体内的“友好”微生物喂的饱饱的,而让“敌对”的微生物饿肚子。
比如某些膳食纤维可以充当肠道益生菌生长的底物,被称为益生元。洋葱、蒜、香蕉、燕麦等中含有较多益生元,可以适当多吃。

相反,过量的饱和脂肪和食品添加剂如聚山梨酯 80、羧甲基纤维素,会滋养导致炎症的微生物、抑制抗炎微生物,容易引起肠道炎症,食用时最好克制。
而少数难治的肠道疾病患者,则需要更烈的猛药:粪便菌群移植。比如,复发性艰难梭菌感染患者通过手术移植、胶囊吞服的方式,接纳健康人捐献的洁净粪便,治疗有奇效。

研究者也已开始研发针对溃疡性结肠炎,帕金森氏病等的粪便移植疗法,效果仍有待观察。
不过,粪便胶囊未免恶心,对免疫功能低下者也有较高的安全风险。对健康的普通人来说,平时保养好自己的肠道菌群,胜过有一天不得不吃别人的翔。
本文来自微信公众号:大象公会(ID:idxgh2013),作者:朱不换